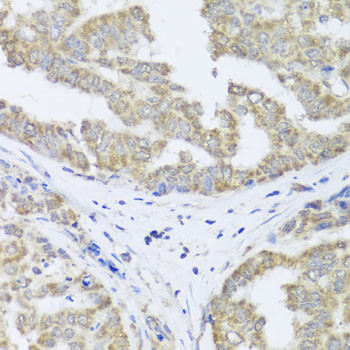
TIMM10B Antibody in Immunohistochemistry (Paraffin) (IHC (P))

Search
Invitrogen
TIMM10B Polyclonal Antibody
{{$productOrderCtrl.translations['antibody.pdp.commerceCard.promotion.promotions']}}
{{$productOrderCtrl.translations['antibody.pdp.commerceCard.promotion.viewpromo']}}
{{$productOrderCtrl.translations['antibody.pdp.commerceCard.promotion.promocode']}}: {{promo.promoCode}} {{promo.promoTitle}} {{promo.promoDescription}}. {{$productOrderCtrl.translations['antibody.pdp.commerceCard.promotion.learnmore']}}
图: 1 / 4
TIMM10B Antibody (PA5-97081) in IHC (P)




Please note: We are reviewing Western blot images included in the antibody testing data in our catalog, including those provided by third parties. Unless expressly labeled or annotated as “raw-unedited”, Western blot images included in the antibody testing data in our catalog may have been edited, optimized or otherwise adjusted for presentation.
产品信息
PA5-97081
种属反应
已发表种属
宿主/亚型
分类
类型
抗原
偶联物
形式
浓度
规格
纯化类型
保存液
内含物
保存条件
运输条件
RRID
产品详细信息
Immunogen sequence: MERQQQQQQQ LRNLRDFLLV YNRMTELCFQ RCVPSLHHRA LDAEEEACLH SCAGKLIHSN HRLMAAYVQL MPALVQRRIA DYEAASAVPG VAAEQPGVSP SGS; Positive Samples: 293T, HepG2, BT-474, HT-1080; Cellular Location: Mitochondrion inner membrane, Peripheral membrane protein
靶标信息
FXC1, or TIMM10B, belongs to a family of evolutionarily conserved proteins that are organized in heterooligomeric complexes in the mitochondrial intermembrane space. These proteins mediate the import and insertion of hydrophobic membrane proteins into the mitochondrial inner membrane.
仅用于科研。不用于诊断过程。未经明确授权不得转售。
生物信息学
蛋白别名: Fracture Callus 1; fractured callus 1; fractured callus expressed transcript 1; Mitochondrial import inner membrane translocase subunit Tim10 B; Mitochondrial import inner membrane translocase subunit Tim9 B; small zinc finger-like protein; Tim10b; TIMM10B
基因别名: Fxc1; Tim10b; Tim9b; Timm10b; Timm9b
UniProt ID: (Mouse) Q9WV96
Entrez Gene ID: (Mouse) 14356